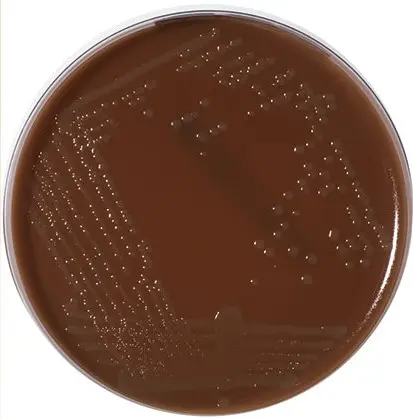
محیط کشت لوینتال چیست

ابزار و وسایل آزمایشگاهی شامل، محلول ها کیت ها,ویکی ژن
محیط کشت لوینتال (Levinthal’s Medium): ترکیب، اصول، روش آمادهسازی، نتایج و موارد استفاده
مقدمهای بر محیط کشت لوینتال
محیط کشت لوینتال برای کشت گونههای هموفیلوس (Haemophilus) استفاده میشود. جنس هموفیلوس شامل تعدادی گونه است که باعث طیف گستردهای از عفونتها میشوند، اما مورفولوژی مشترک و نیاز به فاکتورهای خونی در طول رشد دارند که نام این جنس از آنجا گرفته شده است. جنس هموفیلوس نشان دهنده گروه بزرگی از باکتریهای میلهای گرم منفی است که در آگار حاوی خون رشد میکنند. خون دو فاکتور را فراهم میکند که بسیاری از گونههای هموفیلوس برای رشد به آنها نیاز دارند: فاکتور X و فاکتور V.
ترکیب محیط لوینتال
| مواد تشکیل دهنده | گرم در لیتر |
| پپتیک دایجست (Peptic digest) بافت حیوانی | 10 |
| عصاره گوشت گاو | 10 |
| کلرید سدیم | 5 |
| باسیتراسین (Bacitracin) | 0.3 |
| آگار | 20 |
pH نهایی (در دمای 25 درجه سانتیگراد): 0.2 ± 7.6
اصول محیط کشت لوینتال
- خون دست نخورده خرگوش یا خون انسان حاوی دو فاکتور مهم یعنی فاکتور X و فاکتور V است که برای رشد گونههای آنفلوانزا ضروری هستند.
- فاکتور X یک ماده پایدار در گرما است، هیمین (Hemin) مرتبط با هموگلوبین بوده، در حالی که فاکتور V یک کوآنزیم حساس به حرارت مربوط به نیکوتینآمید آدنین دینوکلئوتید (Nicotinamide Adenine Dinucleotide (NAD)) است.
- سایر مواد مغذی مانند ترکیبات نیتروژن از طریق پپتیک دایجست بافت حیوانی و عصاره گوشت گاو موجود در محیط تامین میشوند.
- کلرید سدیم به حفظ تعادل اسمزی (Osmotic) محیط کمک میکند.
- باسیتراسین اضافه شده، فلور (Flora) طبیعی را مهار میکند، که این امر باعث افزایش بازیابی گونههای هموفیلوس میشود.
- گونههای هموفیلوس بیماریزا را میتوان با تعیین نیازهای رشد در شرایط آزمایشگاهی برای فاکتورهای X و V و با واکنشهای همولیتیک (Hemolytic) در آگار به طور احتمالی شناسایی کرد.
روش آمادهسازی محیط کشت لوینتال
- 45 گرم از محیط را در 1000 میلیلیتر آب مقطر بریزید.
- آن را حرارت دهید تا به جوش آید و محیط کاملا حل شود.
- محیط را در مقادیر 100 میلیلیتر توزیع کرده و با اتوکلاو کردن در فشار 15 پوند (121 درجه سانتیگراد) به مدت 15 دقیقه آنها استریل کنید.
- آن را تا دمای 50 درجه سانتیگراد خنک و 5 میلیلیتر خون استریل خرگوش یا انسان را به 100 میلیلیتر محیط اضافه کنید.
- مخلوط را در حمام آب جوش (Boiling water bath) گرم کنید.
- اجازه دهید رسوبات ته نشین شوند و مایع رویی شفاف شود.
- آن را داخل پتری دیشهای (Petriplate) استریل بریزید.
تفسیر نتایج در محیط کشت لوینتال
| ارگانیسمها | رشد |
| هموفیلوس آنفولانزا (Haemophilus influenza) | رشد بسیار زیاد؛ سویههای کپسولدار، کلنیهای شفاف با ظاهر رنگین کمانی مشخص را ایجاد میکنند. سویههای غیر کپسولدار، شفاف و مایل به آبی بوده و ظاهر غیر رنگین کمانی دارند. |
| استافیلوکوکوس اورئوس (Staphylococcus aureus) | رشد بسیار زیاد |
| استرپتوکوک پیوژنز (Streptococcus pyogenes) | رشد بسیار زیاد |
موارد استفاده از محیط کشت لوینتال
- پایه محیط کشت لوینتال با افزودن خون برای کشت گونههای هموفیلوس استفاده میشود.
- میتوان از آن برای کشت انواع ارگانیسمهای سختپسند (Fastidious) استفاده کرد.
محدودیت محیط کشت لوینتال
- توصیه میشود برای شناسایی کامل، آزمایشات بیوشیمیایی، ایمونولوژیک (Immunologic)، مولکولی یا طیفسنجی جرمی (Mass spectrometry) روی کلنیهای حاصل از کشت خالص انجام شود.
جهت خرید و یا استعلام قیمت با ما تماس بگیرید یا در واتسپ پیام بزارید
همچنین بخوانید:
- پتری دیش چیست؟ تعریف، قطعات، انواع، موارد استفاده
- محیط کشت لون اشتاین جانسون (LJ): ترکیب، اصول، روش آمادهسازی، نتایج و موارد استفاده
- محیط کشت لوفلر (Loeffler Medium): ترکیب، اصول، روش آمادهسازی، نتایج و موارد استفاده
- تایر مارتین آگار اصلاح شده (Modified Thayer Martin Agar): ترکیب، اصول، روش آمادهسازی، نتایج و موارد استفاده
مترجم: صادق حسینیکیا





